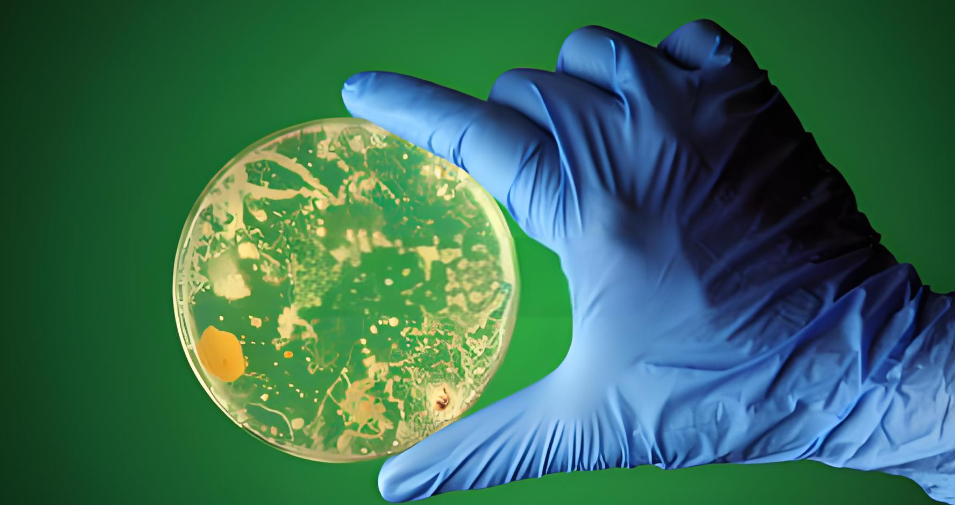
凯杰qiagen质粒提取试剂盒操作步骤

北京百奥创新科技有限公司代理商
9 年
手机商铺
商家活跃:
产品热度:
- NaN
- 0
- 0
- 2
- 2
推荐产品
技术资料/正文
凯杰qiagen质粒提取试剂盒操作步骤
184 人阅读发布时间:2024-08-28 11:06
凯杰qiagen质粒提取试剂盒,来自凯杰Qiagen,是世界各地研究人员公认的最好的核酸纯化品牌之一。良好的口碑、稳定可靠的质量,每年40%的强劲增长支持Qiagen强大的科研力量专注于核酸纯化技术的不断改革和创新,使得Qiagen的产品系列广泛而全面,更成为众多小品牌模仿和学习的目标。
1.从琼脂平板上挑取一个单菌落 接种到2-5mL含有适当抗生素的LB液体培养基中生长。将液体培养基置于37℃,300rpm的摇床中振荡8小时。
2.用LB培养基以1/500~1/1000的比例稀释含菌落的培养基。若为了获得高用拷贝 质粒100-200ul含菌落液体培养基接种到100mlLB培养基中;若为了获得低拷贝质粒,用250~500ul含菌落培养基接种到250mlLB培养基中。让其在37℃,300rpm的摇床中振荡12-16小时。

3.添加10mlBufferP2,剧烈晃动离心管4-6次使其彻底混匀,室温放置5min。
4.加入10ml冰浴的BufferP3到此溶菌产物中,晃动离心管4-6次使其混匀。
5.将溶菌产物倒入针口密封的过滤器中,室温放置10min,不要插入活塞。
6.打开针口的密封盖,轻轻挤压活塞将溶菌产物过滤到一新的50ml离心管中
7.添加2.5mlBufferER到过滤的溶菌液中,充分混匀10次后冰上孵育30min。
1.将QIAGEN-tip500的柱子挂在另一离心管上,加入10mlBufferQBT,让管中溶液慢慢滴下排空。
2.将上一个步骤中的第7步冰上孵育的溶菌液加入QIAGEN-tip柱子中让其透过树脂慢慢滴下。
3.用2X30mlBufferQC洗QIAGEN-tip柱。
4.再用15mlBufferQN洗脱DNA,用离心管收集DNA洗脱液。
5.加入10.5ml异丙醇到洗脱液中使DNA沉淀下来,混匀。15000Xg,4℃离心30min,
离心后小心倒出上清液。
更多有关凯杰qiagen质粒提取试剂盒请联系凯杰qiagen代理——北京百奥创新科技有限公司!
一、凯杰qiagen质粒提取试剂盒操作步骤一
【细菌培养物的生长】1.从琼脂平板上挑取一个单菌落 接种到2-5mL含有适当抗生素的LB液体培养基中生长。将液体培养基置于37℃,300rpm的摇床中振荡8小时。
2.用LB培养基以1/500~1/1000的比例稀释含菌落的培养基。若为了获得高用拷贝 质粒100-200ul含菌落液体培养基接种到100mlLB培养基中;若为了获得低拷贝质粒,用250~500ul含菌落培养基接种到250mlLB培养基中。让其在37℃,300rpm的摇床中振荡12-16小时。
二、凯杰qiagen质粒提取试剂盒操作步骤二
【细菌的收获和裂解】
1.在6000Xg,4℃条件下离心15min,收获细菌。
2.加入10mlBufferP1重悬细菌。3.添加10mlBufferP2,剧烈晃动离心管4-6次使其彻底混匀,室温放置5min。
4.加入10ml冰浴的BufferP3到此溶菌产物中,晃动离心管4-6次使其混匀。
5.将溶菌产物倒入针口密封的过滤器中,室温放置10min,不要插入活塞。
6.打开针口的密封盖,轻轻挤压活塞将溶菌产物过滤到一新的50ml离心管中
7.添加2.5mlBufferER到过滤的溶菌液中,充分混匀10次后冰上孵育30min。
三、凯杰qiagen质粒提取试剂盒操作步骤三
【质粒DNA的纯化】1.将QIAGEN-tip500的柱子挂在另一离心管上,加入10mlBufferQBT,让管中溶液慢慢滴下排空。
2.将上一个步骤中的第7步冰上孵育的溶菌液加入QIAGEN-tip柱子中让其透过树脂慢慢滴下。
3.用2X30mlBufferQC洗QIAGEN-tip柱。
4.再用15mlBufferQN洗脱DNA,用离心管收集DNA洗脱液。
5.加入10.5ml异丙醇到洗脱液中使DNA沉淀下来,混匀。15000Xg,4℃离心30min,
离心后小心倒出上清液。
6.洗DNA用5ml无内毒素-70%乙醇 (添 加40ml96%-100%乙醇到试剂盒的无内毒素水中),15000Xg,4℃离心10min。小心倒出上清液不要碰到质粒。
7.烘干离心管底部的质粒5-10min。用500ul无内毒素的BufferTE重新溶解DNA。
四、凯杰qiagen质粒提取试剂盒目录表
| 货号 | 产品名称 | 规格 |
| 12362 | EndoFree Plasmid Maxi Kit (10) | 10T |
| 12381 | EndoFree Plasmid Mega Kit (5) | 5T |
| 12391 | EndoFree Plasmid Giga Kit (5) | 5T |
更多有关凯杰qiagen质粒提取试剂盒请联系凯杰qiagen代理——北京百奥创新科技有限公司!






